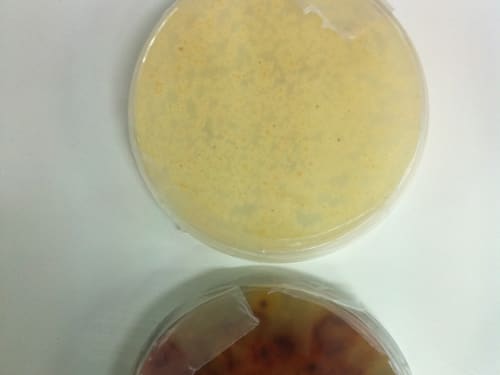

2011
Sustainable Technologies
This is the creation and transmission of electricity via wireless, through the use of diesel and petrol powered cars to power up communities and industries. A lot of alternative ways of creating electrical energy have been created and most of them cost of a lot of money to set up and install,
Wind energy systems won't be popularly accepted until they are economically competitive with conventional electrical generation. Current wind generated power costs about three times that generated with coal or natural gas.
Drawbacks to current wind turbines include:
High cost.
Little power generated in low wind.
Birds killed by rotors.
This concept addresses growing interest and demand for hydrogen for mobile applications and as a competitive source of energy for the combustion engine 1. While hydrogen may make an ideal fuel, it is rare in natural occurrence. Future production must come from other energy sources and face market efficiency.
A major problem with mobile phones and other portable multimedia devices (MP3, Media players) is that these devices need some standby time during the charging process. Obviously the user has to plug the device into a power socket to charge it. During this charging time the device's portability is lost and ultimately its usability suffers.
Facts: Water comprises two-thirds of the human body. Water comprises three-fourths of the human brain. Clean water is essential for life on Earth. Stormwater runoff from streets and roads is the major uncontrolled source of water pollution in urban areas. The recognition of this source of water pollution is ever increasing.
The Waterdance Valve is a water-saving device that allows users to turn on the hot water faucet or shower, capture and cleanly store the cold water runoff normally wasted while waiting for the water to get hot, and then use that captured water as needed from the same faucet, all while requiring no electricity,
In the last decade organic crops are gaining momentum in international markets due to increased public awareness about the harmful effects that common pesticides have on the human body and the environment. These crops have to deal in new and innovative ways with the different kinds of insects and microorganisms that attack them, for example,
U.S. patent 7,976,267: “Helix Turbine System and Energy Production Means” is a modified helical vertical axis wind turbine. The invention was designed to be mounted on the peaks of roofs, edges of buildings, or with a conical or dome shaped base at the base to take advantage of the turbulent and accelerated wind energy produced.
Creating a cleaner, healthier, safer world where you may never have to buy gasoline or diesel fuel again, where you could get a check from the electric company instead of a bill and where nuclear power will be unnecessary. Sustainable economies without pain or sacrifice.
Our patent application has been published,
Page 15 of 16